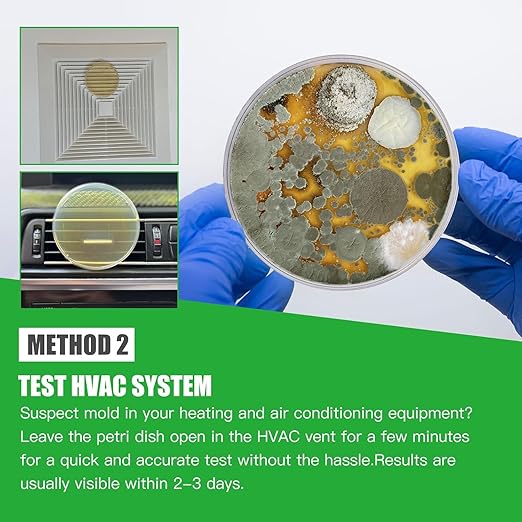
Mold Test Kit for Home Within 6 Individual Tests,DIY Detector at Home,Surface Mold,HVAC,Indoor Air Quality Testing Kits,Black Mold Testing,Includes Detailed Mold Identification Guide and Free Lab

Entimp
Mold Test Kit for Home Within 6 Individual Tests,DIY Detector at Home,Surface Mold,HVAC,Indoor Air Quality Testing Kits,Black Mold Testing,Includes Detailed Mold Identification Guide and Free Lab
Mold Test Kit for Home Within 6 Individual Tests,DIY Detector at Home,Surface Mold,HVAC,Indoor Air Quality Testing Kits,Black Mold Testing,Includes Detailed Mold Identification Guide and Free Lab
Couldn't load pickup availability
About This
- COMPLETE MOLD TESTING KIT: This mold testing kits for home air quality, surface and HVAC system, including 6 agar petri dishes, enough cotton-tipped swabs, enclosed plastic bag,disposable gloves label sticker,detailed identification and removal guide, Laboratory analysis results.This versatile kit can comprehensively test your home for mold, pinpointing various mold types.for easy sample collection and provides accurate and reliable results for peace of mind!
- VERSATILE INDOOR TESTING: With the flexibility to assess both indoor environments.DIY Mold Test Kit for home is equipped for extensive environmental scrutiny, adept at performing indoor testing. It effectively detects unseen mold in living spaces areas, from attic,basement, car, bedroom,bathroom, kitchen, office and HVAC system,any Indoor place surface testing needs!
- THREE TESTING METHODS FOR COMPERHENSIVE ANALYSIS: Our home mold testing kit provides a multifaceted approach to mold detection in your home. Opt for an Indoor Air Quality Test to survey the overall atmosphere, utilize the Air Conditioning & Heating Sample Method for a detailed check of your climate control systems, or select the Surface Sampling Testing Method to directly address and analyze visible mold. This adaptable mold detector kit ensures thorough mold assessment in any area of concern.
- MOLD GUIDE AND FREE LABORATORY ANALYSIS:The Mold Guide helps you identify common types of mold and teaches you how to remove it. We also provide free laboratory analysis. You only need to send us photos of the mold, no need to mail it, and professionals will analyze it for you 24 hours a day.
- ESCORT YOUR SAFETY:After our extensive research, we have provided you with everything you need for mold testing, making the testing more convenient and professional, and protecting the health of your family.